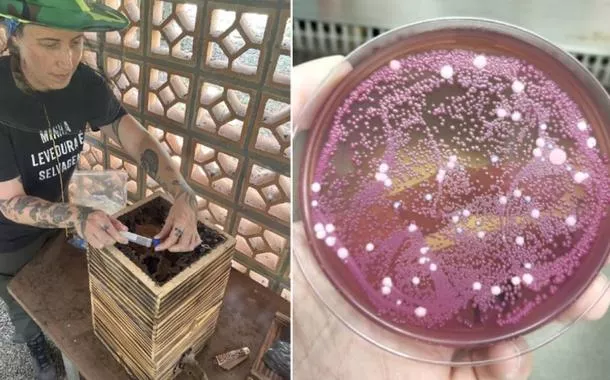

Países amazônicos defenderão fundo para preservar florestas
Reunião da OTCA em Bogotá terá presença de Lula e discutirá COP30
Por Pedro Rafael Vilela, repórter da Agência Brasil - Impulsionados por Colômbia e Brasil, os países da Organização do Tratado de Cooperação Amazônica (OTCA) devem assinar, na próxima sexta-feira (22), uma declaração conjunta de apoio ao Fundo Florestas Tropicais para Sempre (TFFF, da sigla em inglês), que será lançado durante a Conferência das Nações Unidas sobre Mudanças Climáticas, a COP30, em Belém, no fim do ano.
O fundo será um mecanismo de financiamento destinado a preservar esses biomas florestais, presentes em cerca de 70 países, e que são cruciais para a regulação do regime de chuvas e captura de carbono na atmosfera.
A declaração é um dos documentos a serem referendados durante uma nova edição da Cúpula da Amazônia, que será realizada em Bogotá, na Colômbia, na próxima sexta-feira (22), e contará com a participação do presidente Luiz Inácio Lula da Silva, que embarca para o país no dia anterior.
Lula e o presidente colombiano Gustavo Petro se encontrarão na cúpula, que prevê um encontro com organizações da sociedade civil para receber sugestões de medidas de enfrentamento ao aquecimento global e outros desafios ambientais urgentes.
Além da declaração em favor do TFFF, a reunião deverá aprovar a Carta de Bogotá, reforçando metas e compromissos dos países em ações como combate ao desmatamento e desenvolvimento sustentável do bioma amazônico.
A iniciativa repete a metodologia adotada há dois anos, quando o encontro de países amazônicos ocorreu em Belém.
"Será uma declaração com ênfase no tema da mudança do clima, mas ela também pretende fazer um balanço de todas as ações que foram implementadas desde a cúpula de Belém, em 2023", explicou o embaixador João Marcelo Queiroz, diretor do Departamento de América do Sul do Ministério das Relações Exteriores (MRE), em coletiva de imprensa para dar detalhes sobre a cúpula.
Na Cúpula em Bogotá, além de Lula e Petro, está confirmada presença da vice-presidente do Equador, Maria José Pinto. Os demais países deverão ser representados por chanceleres.
Estratégia diplomática
No caso da carta-conjunta sobre o TFFF, o Itamaraty pretende, como estratégia diplomática por meio do endosso político dos países amazônicos, impulsionar o alcance do novo fundo, que pode captar cerca de US$ 125 bilhões (cerca de R$ 680 bilhões), entre recursos públicos e privados, que serão reinvestidos em ações de preservação florestal.
"É uma iniciativa inovadora no sentido de que vai proporcionar financiamento para os países em desenvolvimento que têm florestas tropicais. Vai ser um mecanismo baseado em resultados, ou seja, os países que demonstrarem que conservaram suas florestas vão ser remunerados em até US$ 4 por hectare", detalhou Patrick Luna, chefe da Divisão de Biodiversidade do MRE.
O valor de US$ 4 por hectare de floresta preservada, no caso brasileiro, poderia gerar um aporte de recursos, segundo o diplomata, em valores até sete vezes maiores que o orçamento anual do Ministério do Meio Ambiente e Mudança do Clima (MMA), atualmente em cerca de R$ 3,5 bilhões, alcançando, potencialmente, cifras de mais de R$ 24 bilhões a cada ciclo de pagamento.
Idealizado pelo Brasil, com apoio de países como a própria Colômbia, além de Noruega, Reino Unido, França, Emirados Árabes Unidos, o fundo também vem sendo apoiado por nações que contam com enormes extensões de florestas tropicais, como Gana, República Democrática do Congo (RDC), Malásia e Indonésia.
Em maio, um evento na RDC endossou apoio dos países da Bacia do Congo, na África, ao novo mecanismo de financiamento. A ideia é que um evento similar ocorra também em países abrangidos pela Bacia do Mekong e pela Ilha de Bornéu, na Ásia. As duas bacias, juntamente com a Bacia da Amazônia, reúnem as áreas florestais de maior biodiversidade no planeta Terra.
Investimento verde
"A contribuição ao fundo não vai ser uma doação, vai ser investimento. Tanto as empresas quanto os países que fizerem aportes ao fundo vão ser remunerados anualmente com uma taxa competitiva de mercado, como se tivessem comprado títulos de uma dívida de um fundo triple A", destacou Patrick Luna. Fundos triple A têm baixo risco de inadimplência.
Pelas regras, parte do lucro volta ao investidor, como um investimento regular, e o excedente será direcionado aos países que protegerem suas florestas tropicais, proporcionalmente à área preservada.
O modelo, segundo o governo brasileiro, permite que investidores recuperem seus recursos, com remuneração compatível com as taxas normais de mercado, ao mesmo tempo em que contribuem para a preservação florestal e a redução de emissões de carbono.
O Fundo Florestas Tropicais para Sempre também terá, entre suas regras, o repasse direto de 20% do total de seus recursos para comunidades de povos indígenas e tradicionais que vivem e preservam esses biomas, reforçando o papel comunitário na preservação.
Todas as ações deverão ser coordenadas por um comitê, a ser criado com representantes dos países que fazem parte do grupo de trabalho que está construindo a proposta.